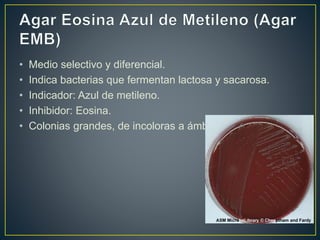
• Medio selectivo y diferencial.
• Indica bacterias que fermentan lactosa y sacarosa.
• Indicador: Azul de metileno.
• Inhibidor: Eosina.
• Colonias grandes, de incoloras a ámbar.
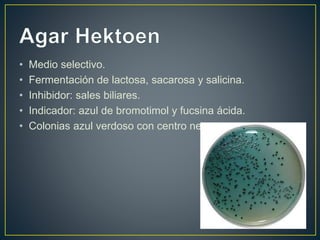
• Medio selectivo.
• Fermentación de lactosa, sacarosa y salicina.
• Inhibidor: sales biliares.
• Indicador: azul de bromotimol y fucsina ácida.
• Colonias azul verdoso con centro negro.
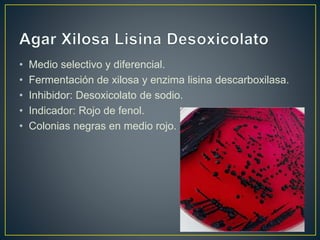
• Medio selectivo y diferencial.
• Fermentación de xilosa y enzima lisina descarboxilasa.
• Inhibidor: Desoxicolato de sodio.
• Indicador: Rojo de fenol.
• Colonias negras en medio rojo.

Este documento describe las características de las bacterias del género Salmonella, incluyendo Salmonella typhi, Salmonella typhimurium y Salmonella enteritidis. Explica sus síntomas, medios de cultivo, pruebas para su identificación, tratamiento y medidas de prevención.